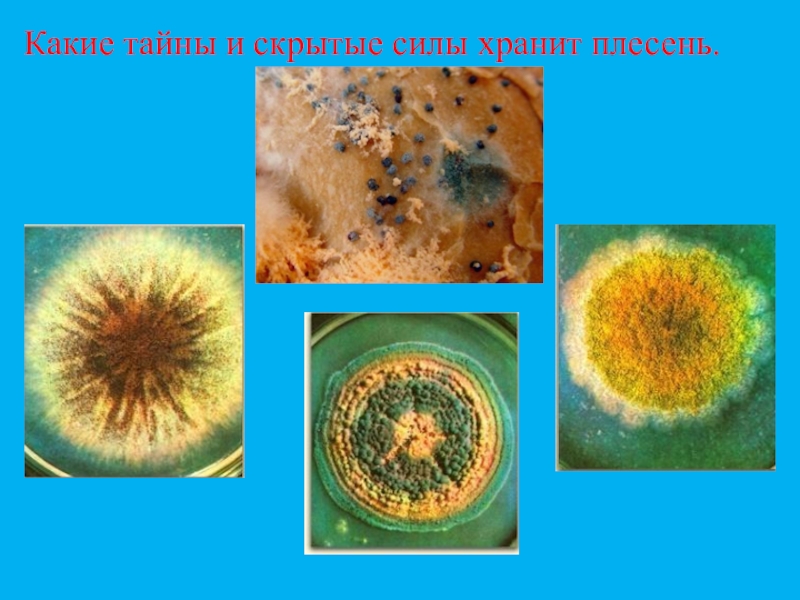

- Главная
- Разное
- Образование
- Спорт
- Естествознание
- Природоведение
- Религиоведение
- Французский язык
- Черчение
- Английский язык
- Астрономия
- Алгебра
- Биология
- География
- Геометрия
- Детские презентации
- Информатика
- История
- Литература
- Математика
- Музыка
- МХК
- Немецкий язык
- ОБЖ
- Обществознание
- Окружающий мир
- Педагогика
- Русский язык
- Технология
- Физика
- Философия
- Химия
- Шаблоны, фоны, картинки для презентаций
- Экология
- Экономика
Презентация, доклад по биологии на тему Плесневые грибы и дрожжи
Содержание
- 1. Презентация по биологии на тему Плесневые грибы и дрожжи
- 2. Факты…Все мировые информационные агентства планеты передали тревожное
- 3. Китайской армии двухтысячелетних терракотовых воинов - одному
- 4. Представить числа в виде суммы разрядных слагаемых: 38,51,77,44,44,88.
- 5. Как?Кто?Что?Где?Какое?
- 6. Она появилась на Земле 200 млн. лет назад
- 7. Слайд 7
- 8. Слайд 8
- 9. Споры некоторых грибков могут становиться причиной плохого
- 10. Какие тайны и скрытые силы хранит плесень.
- 11. Кейс Сережа прочитал в газете, что некоторые
- 12. Вопросы кейса:Какие группы грибов по способу питания
- 13. Слайд 13
- 14. Плесневые грибыМицелий пенициллина состоит из разветвленных нитей,
- 15. Слайд 15
- 16. Слайд 16
- 17. Слайд 17
- 18. Слайд 18
- 19. ВЫБЕРИ ПРАВИЛЬНЫЙ ОТВЕТ, ЗАПИШИ БУКВУ ОТВЕТА В
- 20. 4.Дрожжи размножаютсяА) спорамиБ) почкованиемВ) мицелием5.Симбиоз – это
- 21. 7.К пластинчатым грибам относитсяЦ) лисичкаО) подосиновикМ) маслёнок8.Половое
- 22. Слайд 22
- 23. ДОМАШНЕЕ ЗАДАНИЕ§15, ответить на вопросы.Индивидуальное задание на
Слайд 1МБОУ «СОШ№5» г. Курчатова
Плесневые грибы и дрожжи
Учитель биологии высшей квалификационной категории
Матвеева
Слайд 2Факты…
Все мировые информационные агентства планеты передали тревожное сообщение – гибнут рукописи
Слайд 3Китайской армии двухтысячелетних терракотовых воинов - одному из самых значительных археологических
Факты…
Слайд 9Споры некоторых грибков могут становиться причиной плохого самочувствия, головокружения и отравления,
Слайд 11Кейс
Сережа прочитал в газете, что некоторые лекарства можно получать из
Помогите Мише и Сереже в решении проблемы: объясните, где должны были искать грибы школьники.
Слайд 12Вопросы кейса:
Какие группы грибов по способу питания вы знаете?
Назовите представителей плесневых
Какое строение имеет пеницилл (рассмотреть под микроскопом препарат плесени)?
Какое строение имеет мукор (рассмотреть под микроскопом препарат плесени) ?
Какое строение имеют дрожжи?
Каким способом плесневые грибы размножаются?
Для чего используют плесневые грибы и дрожжи?
Слайд 14Плесневые грибы
Мицелий пенициллина состоит из разветвленных нитей, разделенных перегородками на клетки,
Этот гриб встречается в виде плесени (зеленого, сизого, голубого цвета) на почве и продуктах растительного происхождения (на плодах, овощах, варенье, томатной пасте и др.). Некоторые виды пеницилла используются для приготовления пенициллина— одного из наиболее известных антибиотиков.
Слайд 16
Одноклеточные грибы не имеют мицелия и представляют собой неподвижные клетки овальной формы размером 2—10 мкм с одним ядром.
Размножаются дрожжи почкованием или делением.
Наибольшее практическое значение имеют пекарские дрожжи, представленные несколькими сотнями рас — винными, пивными, хлебопекарными и др. Они применяются в пивоварении, хлебопечении, производстве спирта. Некоторые виды дрожжей способны вызывать у людей заболевания.
Слайд 19ВЫБЕРИ ПРАВИЛЬНЫЙ ОТВЕТ, ЗАПИШИ БУКВУ ОТВЕТА В ТАБЛИЦУ. ЕСЛИ ОТВЕТИЛ ПРАВИЛЬНО,
1.По способу питания грибы похожи на животных, так как:
А) способны к фотосинтезу
Г) питаются готовыми органическими веществами
У) поглощают пищу путём всасывания
2.Оболочка клеток большинства грибов содержит:
Р) хитин
О) целлюлозу
Т) муреин
3.Симбиоз грибницы с корнем дерева называется
Ж) мицелий
Д) плодовое тело
И) микориза
Слайд 204.Дрожжи размножаются
А) спорами
Б) почкованием
В) мицелием
5.Симбиоз – это тип взаимоотношений между двумя
К) выгодно одному из организмов
О) не выгодно обоим
Н) выгодно обоим
6.Гриб, питающийся органическими веществами отмерших организмов
М) мукор
И) трутовик
К) фитофтора
Слайд 217.К пластинчатым грибам относится
Ц) лисичка
О) подосиновик
М) маслёнок
8.Половое размножение у грибов происходит
А) при слиянии специализированных клеток
Г) с помощью спор
У) почкованием
Слайд 23ДОМАШНЕЕ ЗАДАНИЕ
§15, ответить на вопросы.
Индивидуальное задание на выбор:
а) подготовить презентацию «В
б) устное сообщение «Грибы-рекордсмены» (необычные грибы);
в) сказка собственного сочинения по теме урока.